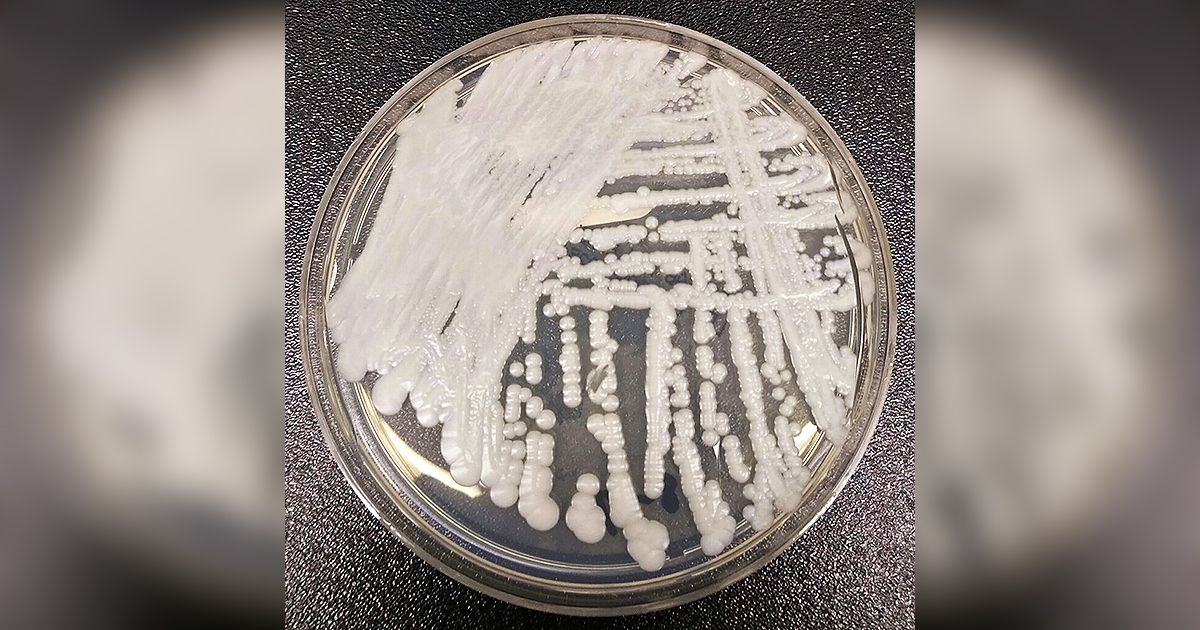

"Emergence of Hypervirulent, Carbapenem-Resistant K. pneumoniae in European Hospitals"
The hypervirulent Klebsiella pneumoniae, a superbug endemic to Asia, has seen a 1,000% increase in infections in European hospitals since 2021, with cases rising from 12 to 143. This bacteria, resistant to last-line antibiotics, is causing concern due to its ability to infect healthy individuals and its association with hepatic abscesses, sepsis, meningitis, and pneumonia. The European Centre for Disease Control warns of its significant impact on morbidity and mortality, with clusters of cases reported in 10 European countries. This highlights the growing threat of antibiotic-resistant superbugs, which are projected to cause 10 million deaths annually by 2050.